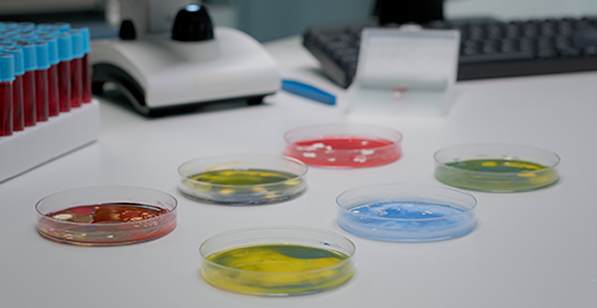
MEDICINA

MEDICINA
Gordana Tomljenović
Mikroorganizmi od kojih zavisimo
Virom važan koliko i mikrobiom
Virusi nisu samo patogeni, već deluju slično kao i korisne simbiotske bakterije, i mogu veoma blagotvorno da utiču na ljudsko zdravlje

Gotovo da je već opšte poznat veliki značaj mikrobioma - ogromnog zbira raznovrsnih bakterija i gljivica koje naseljavaju ljudski organizam - i za život čoveka, i za život na planeti. Štaviše, naučno saznanje da ove mikrobne zajednice naseljavaju praktično svako okruženje i da imaju centralnu ulogu u ljudskom zdravlju (i oboljevanju), kao i u biogeohemijskim procesima života na Zemlji, smatra se revolucionarnim napretkom u biološkim naukama. To je zato što je zdrav mikrobiom sastavni deo čovekove fiziologije, simbiotski delujući na njegovu biologiju, na svaki čovekov organski sistem: pomaže u razgradnji, apsorpciji i asimilaciji esencijalnih nutrijenata iz hrane; utiče na metabolizam (pa time i na rizik nastanka gojaznosti i razvoj dijabetesa); ima ključnu ulogu u regulaciji imunološkog sistema i prevenciji infekcija; moduliše inflamatorne procese, potencijalno smanjujući rizik od hroničnih zapaljenskih bolesti; deluje na funkcionisanje kože te može da utiče i na stanja poput ekcema i akni, a od uticaja je čak i na mentalno zdravlje, delujući na funkcije mozga i na raspoloženje.
Manje je, međutim, poznato da je podjednako važan deo ove kompleksne mikrobne zajednice i virom, kolekcija različitih virusa koja takođe nastanjuje ljudsko telo, i planetu. Smatra se, štaviše, da su virusi najbrojnije i najraznovrsnije žive jedinke na Zemlji, te da je i ljudski virom ogroman, složen i veoma heterogen. Sa sekvenciranjem ljudskog genoma i razvojem drugih savremenih metoda i o značaju viroma za ljudsko zdravlje se poslednjih godina sve više zna, ali se istovremeno ukazuje i na gotovo nesaglediv obim još neistraženih virusa i njihovih delovanja.

Korisni virusi
Virusologija će, naravno, i dalje biti osnovna medicinska disciplina koja istražuje životno ugrožavajuće patogene. U toj nauci je odavno poznato da virusi predstavljaju sasvim poseban oblik života, sa specifičnostima koji ih veoma razlikuju od drugih mikroorganizama. Pre svega je reč o tome da su virusi evoluiranjem dostigli najsavršeniji oblik energetskog intraćelijskog parazitizma: odlikuje ih sposobnost da “primoraju” ćeliju domaćina da metabolizam preusmeri sa sopstvenog održanja ka stvaranju novih jedinki virusa, ne napuštajući je dok je potpuno ne iscrpu i unište; razmnoženi, po izlasku iz uništene ćelije, nastavljaju da inficiraju nove ćelije, što uzrokuje oboljevanje napadnutog organizma. Iz tog razloga se ranije dugo verovalo da su ovi nanometarski mikrobi odgovorni isključivo za razvoj različitih bolesti i drugih patoloških procesa.

|
U novije vreme, istraživanja ukazuju da je i ljudski virom jedna od ključnih komponenti čovekovog biološkog sastava, i da virusi takođe učestvuju u oblikovanju čovekovog zdravlja na vrlo važne i složene načine, koji se još istražuju. Štaviše, neverovatan napredak u razumevanju interakcija između virusa i njihovih domaćina, ukazuje na to da virom nije samo skup patogena već da sadrži i viruse koji deluju slično kao simbiotske bakterije. Na primer, danas je poznato da virusi mogu da komuniciraju sa bakterijama (crevnog) mikrobioma, potencijalno delujući na bakterijske zajednice i njihove funkcije, što može da utiče na varenje, metabolizam, pa i na raspoloženje. Isto kao i mikrobiom, i virom utiče na imune odgovore ljudskog organizma, čime održava njegovo zdravlje, odnosno potencijalno doprinosi razvoju različitih oboljenja, uključujući autoimuna stanja, malignitete i metaboličke poremećaje. Pritom, kao i kad je reč o bakterijama, efekti koje virusi imaju na ljudsko zdravlje zavise od lokacije tkiva koje naseljavaju, od mikrookruženja u telu domaćina i samog domaćina. Svi ovi faktori direktno utiču na to da li virus deluje blagotvorno, štetno, ili ostaje neutralan prema domaćinu.
Za bliže upoznavanje delovanja viroma na ljudsko zdravlje posebno su značajne inovacije i nove tehnike u oblasti sekvenciranja DNK, genetskog materijala živih bića. Uz ovo, međutim, treba pomenuti još jednu osobenost virusa, u poređenju sa drugim mikroorganizmima: za razliku od svih drugih živih ćelija na planeti, koje sadrže obe nukleinske kiseline (genetskog materijala), DNK (dezoksiribonukleninsku) i RNK (ribonukleinsku), virusi sadrže samo jednu od njih. Drugim rečima, sva živa bića svoj genetički materijal nose u obliku DNK, dok neki od virusa sadrže samo RNK. Na osnovu toga se, između ostalog, dele i na DNK viruse, i RNK viruse: relativno stabilne DNK viruse, poput virusa variole vere, koji se uglavnom ne menjaju, i vrlo promenjljive RNK viruse, poput izazivača bolesti Covid-19, koronavirusa SARS-CoV-2, koji veoma lako mutiraju (evoluiraju) prilikom umnožavanja. Otuda i činjenica da se RNK virusi ljudskog viroma (iz tehničkih razloga) ređe istražuju u poređenju sa DNK virusima.
Metagenomika i virusi
Poslednjih godina, zahvaljujući metagenomskom sekvenciranju DNK živih bića i drugim savremenim metodama, istraživanja ljudskog viroma obelodanilo je mnoge nove aspekte na tom planu, a posebno je značajno to što je metagenomika omogućila otkrivanje virusa i u zdravim ljudskim tkivima.
Metagenomsko sekvenciranje je tehnika koja se koristi za analizu genetskog materijala dobijenog direktno iz uzoraka životne sredine, bez potrebe za laboratorijskim uzgojem ciljanih organizama, što naučnicima omogućava sveobuhvatan pregled raznovrsnosti mikroorganizama i njihovih interakcija, pa i otkrivanje vrsta koje je teško kultivisati. Tehnika se sastoji u izdvajanju DNK iz uzorka, njegovom sekvenciranju, a zatim analizi sekvenci radi identifikacije organizama i njihovih funkcija. Zbog ovih prednosti, metagenomsko sekvenciranje se obično koristi u mikrobiološkim istraživanjima životne sredine, istraživanjima u oblasti zdravlja ljudi i biotehnološkim istraživanjima složenih ekosistema.
Inovacije u DNK sekvenciranju veoma su doprinele brzom napretku u istraživanju viroma. Kako se navodi u međunarodnoj studiji “Osvetljavanje značaja humanog viroma za zdravlje i oboljevanje”, objavljenoj 2020. godine u časopisu British Medical Journal, nove tehnike poput “shotgun” sekvenciranja omogućile su analiziranje čitavih virusnih zajednica. Reč je o nasumičnom sekvenciranju prečišćenih virusnih uzoraka koje je prvi put primenjeno na virusne populacije u morskoj void; otkrilo je veoma obilne i raznovrsne virusne genome, kao i veliki deo virusne “tamne materije” - DNK sekvence koje su u dostupnim bazama podataka izgledale kao “prazna mesta”. Već naredne godine je izvedena prva studija celih virusnih zajednica iz ljudskih fekalija, što je ponovo otkrilo veoma bogate i raznovrsne virusne populacije ljudskog tela. Od tad, slične metode genetičkog sekvenciranja se primenjuju u mnogim studijama populacija viroma, otkrivajući mnoštvo ranije nepoznatih virusa i produbljujući naučno razumevanje njihove uloge u ljudskom zdravlju i bolestima.

Raznovrsnost virusa
Tokom poslednje decenije, istraživanja ljudskog viroma korišćenjem metagenomskog sekvenciranja i drugih novih metoda potvrdila su da je i humani virom veoma raznovrstan, da ga ima na različitim mestima u telu, kao i da svaki virus može da ima višestruke, i štetne i korisne imunomodulatorne efekte na zdravlje domaćina.
U ljudskom viromu, odnosno viromu svih sisara, pored virusa koji su unutrašnjeg porekla (endogeni), postoje i oni koji napadaju (inficiraju) ćelije svog životinjskog domaćina, ali i virusi koji inficiraju bakterije unutar mikrobioma. U ovom poslednjem slučaju, reč je o bakteriofagama (fagama) koji se razmnožavaju u napadnutim bakterijama. Prema naučnom radu američkog mikrobiologa Kena Kadvela, objavljenom 2016. godine, svi odrasli ljudi hronično su zaraženi višestrukim RNK i DNK životinjskim virusima, u rasponu od tradicionalnih patogena do onih koji su najčešće bezopasni ali mogu da budu štetni za mali deo populacije. S druge strane, milioni osoba širom planete hronično su zaraženi virusima povezanim sa visokim stopama morbiditeta i smrtnosti, kao što su HIV, virus hepatitisa C i virus hepatitisa B.
Takođe, u ljudskom viromu se crevni virom uspostavlja već pri rođenju, i u njemu dominiraju bakteriofagi, virusi koji inficiraju bakterije, dok se eukariotski virusi (koji inficiraju životinje, biljke, gljive i protozoe) postepeno pojavljuju nakon rođenja. Uzgred, dok eukariotski virusi broje oko 100 miliona vrsta, bakteriofagi su neuporedivo brojniji i procenjuju se na oko 10 triliona.

S obzirom na to da napadaju/inficiraju isključivo bakterije, bakteriofagi imaju ključnu ulogu u kontroli bakterijske populacije i održavanju uravnoteženog crevnog mikrobioma - štetne bakterije drže pod kontrolom pa time pomažu i u sprečavanju stanja kao što su inflamatorna bolest creva (IBD - Inflammatory bowel disease) i gojaznost. Štaviše, neki od tih bakteriofaga mogu da uvećaju sposobnost imunog sistema da se bori protiv bakterijskih infekcija, razbijajući spoljašnje membrane štetnih bakterija i oslobađajući antigene koji stimulišu imune odgovore. Kako sve više bakterija razvija rezistentnost na antibiotike, već ima pokušaja da se bakteriofagi ciljano primenjuju za lečenje bakterijskih infekcija kod ljudi, i sve je veće interesovanje za ovaj pristup. Objavljeno je već nekoliko studija o uspešnom lečenja bakterijskih infekcija kod nekolicine pojedinaca, korišćenjem koktela bakteriofaga, što je svakako motiv i za veća klinička ispitivanja.

Takođe, neki virusi koji direktno stupaju u interakciju sa čovekovim imunološkim sistemom čak pomažu u održavanju njegove ravnoteže, potencijalno nas štiteći od bolesti. Štaviše, oni to rade na više načina, između ostalog i tako što podstiču proizvodnju specijalizovanih imunih ćelija, ili menjanje genske ekspresije ćelija, pa čak i suzbijanje antizapaljenskih odgovora. Potencijalno, takvo njihovo delovanje može da smanji rizik od razvoja sekundarnih infekcija i alergijskih odgovora, kasnije u životu. Nasuprot tome, neki virusi mogu da doprinose hroničnoj upali, stalnim aktiviranjem imunoloških puteva. Proučavanjem načina na koje određeni virusi deluju na imuni odgovor, naučnici bi mogli da razvijaju i nove imunološke terapije, pa i nove vakcine koje bolje štite od infekcija.
RANI VIROM |
Zanimljivo je da postoje značajne razlike između crevnih viroma odojčadi i male dece i viroma njihovih majki. Istraživanja koja su identifikovala ove razlike ukazuju, stoga, na to da je crevni virom najmlađih - koji se, podsetimo, uspostavlja već pri rođenju i u kome dominiraju bakteriofagi - pod značajnim uticajem spoljnih faktora kao što su ishrana i okruženje, to jest da se crevni virom ne nasleđuju od majke.
Pokazano je, takođe, da novorođenčad obično nemaju virom koji može da se detektuje odmah pri rođenju, ali da stiču raznovrstan niz virusa, uglavnom bakteriofaga, ubrzo nakon rođenja, što takođe ukazuje da ih verovatno preuzimaju iz okruženja, posredstvom ishrane i kontakata sa bliskim ljudima. |
Virusne terapije
Poput mikrobioma, i zdrav i uravnotežen virom podržava opšte zdravlje čoveka, pomažući i u odbrani od infekcija. Neuravnotežen virom, s druge strane, može da doprinosi lošem zdravlju i razvoju bolesti: promene u viromu povezuju se sa raznim bolestima. Promene u populaciji crevnih virusa, na primer, povezuju se sa inflamatornom bolešću creva (IBD), dijabetesom tipa 2 i hipertenzijom. Utvrđivanje specifičnih promena viroma takođe bi moglo da pomogne razvoj novih dijagnostičkih markera za različite bolesti, kao i da omogući blagovremene i preciznije terapije.
U poslednjoj deceniji već je napravljen značajan napredak u razumevanju ljudskog viroma - proučavanju virusa izvan njihove uloge kao patogena - a dalja istraživanja u tom pravcu mogla bi da dovedu do prave revolucije u oblasti javnog zdravlja i u personalizovanoj medicini. S obzirom na to da je virom svake osobe jedinstven, terapije prilagođene jedinstvenom virusnom sastavu mogle bi da poboljšaju efikasnost lečenja niza stanja, od gastrointestinalnih poremećaja do autoimunih bolesti.
Jedna od takvih mogućnosti je terapija virusima bakteriofagama, u kojoj se bakteriofagi koriste za ciljanje i uništavanje štetnih bakterija, i koja bi mogla da bude moćno sredstvo protiv infekcija otpornih na antibiotike. Bakteriofagi imaju izuzetan potencijal za virusne terapije jer, za razliku od antibiotika koji ubijaju sve bakterije u našim crevima (uključujući i one korisne), fagi su mnogo precizniji, a neki od njih su čak sposobni da ciljaju specifične sojeve bakterija. Zahvaljujući tome, bakteriofagi bi mogli biti ključno oružje čovečanstva protiv takozvanih superbakterija koje se stalno razvijaju.
Nema sumnje da je virom vrlo uzbudljiva nova tema za nauku i za novo razumevanje ljudskog zdravlja. Sa otkrivanjem novih složenih interakcije između virusa i njihovih domaćina, može se očekivati značajan napredak u dijagnostici, lečenju i prevenciji bolesti. Sa napretkom u metagenomskom sekvenciranju DNK, posebno, danas su moguće i velike kliničke studije na ljudima, s ciljem da se promene u specifičnim virusnim populacijama dovedu u vezu sa patogenezom određenih bolesti.
Gordana Tomljenović
Kompletni tekstove sa slikama i prilozima potražite u magazinu
"PLANETA" - štampano izdanje ili u ON LINE prodaji Elektronskog izdanja
"Novinarnica"
|